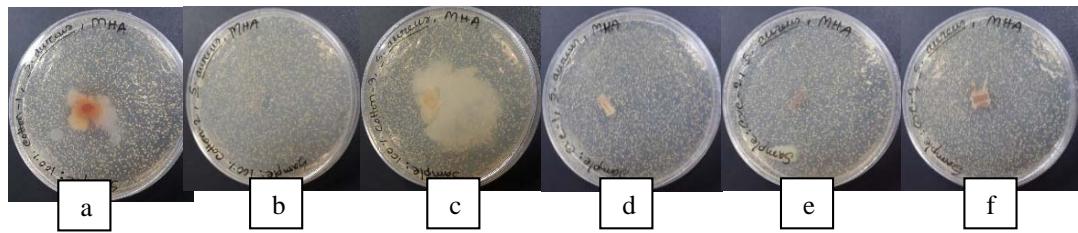

Preventing environmental pollution is the primary goal of obtaining natural dyes from available natural sources.The alkaline extraction process is used to extract dye from Tagetes erecta leaves. In 100% cotton and 60/40 CVC (60% cotton and 40% polyester) single jersey weft knitted fabrics, three different mordants (CuSO4, FeSO4, and K2Cr2O7) are applied simultaneously. At 100°C as well as at room temperature, the dye fixing is done. Various shades of yellow, brown, and light green were produced when the dye was treated with a mordant. Comparing the dye fixed at 100°C to the dye fixed at room temperature, the dye at 100°C displayed dark colors and good fastness qualities.Tagetes erecta dye extract demonstrated significant antibacterial action against gram-positive bacteria (S. aureus), and FTIR was used to identify chemical components and functional groups.
## I. INTRODUCTION
Natural colors are frequently glossy, smooth, and calming to the eyes. A wide range of colors can be produced using natural dyestuffs. Many mordants are used to develop different colors. The artificial dyes don't create a wide range of colors, including unusual colors. Natural dyes are generally nonhazardous to human health, good for the skin, anti-allergenic, and safe for contact with skin(Saravanan P et al., 2013). Natural colors improve with age, but synthetic dyes deteriorate. The generalization that natural colors bleed but do not deteriorate with other textiles does not apply to turmeric. Since natural colors are frequently mothproof, they can alter synthetic dyestuffs in children's clothing. Natural dyes are utilized in textile dyeing, food coloring, beauty products, dye-sensitized solar cells, histology staining, and pH readings, among other things. (Paramasivam et al., 2022).
Since ancient times, Tagetes erecta flowers have been used traditionally. The leaves are applied to boils and used as an antiseptic including for piles, kidney problems, and muscularpain (Samanta & Konar, 2011). Fever and epileptic fits can be treated with the flower. According to Ayurveda, the juice of Tagetes flowers can be utilized to treat several ailments, including astringent, stomachic, carminative, and scabies, as well as liver problems and eye illnesses. They clean the blood, and flower juice is administered to treat bleeding piles. It is also used to treat colds, arthritis, and bronchitis. It was utilized by the Cherokee as a skin cleanser and to produce a yellow color (Shetty et al., 2015).
Flower juice is occasionally used as a blood purifier and piles treatment in numerous countries. In Brazil, Tagetes erecta flowers and leaves serve as a vermifuge. Flowers and leaf tinctures are used as diuretics and carminatives in Mexico. Marigold relieves stomach aches, joint pain, muscle spasms, anemia, irregular periods, and pain in the muscles and bonesin Mexico and Brazil (Shetty et al., 2009). Internally, Tagetes was used to cure indigestion, cough, colic, and diarrhea. It is also used topically for ulcers, eczema, rheumatism, and painful eyes (Elumalai et al., 2012). When metallic salts are employed as a mordant mix with the fabric and dyes, metal complexes are formed. After mordanting, the metal salts adhere to the fibers and entice organic molecules there where they can bond with the fibers and get bonded to them. After that, it creates coordinating complexes to make a linkage between the molecules of dye and the fiber itself (Patil et al., 2016). A specific mordant that can react chemically with functional groups found in natural dyes and held together by coordinated or covalent interactions, hydrogen bonds, and other interactional forces combines with ferrous sulphate or other types of metallic mordants that are bonded to any fiber substances (Saravanan et al., 2013). In acid-base titrations, the methanolic extract of Tageteserecta flower is employed as an acid-base indicator. Indicators for titration displayed discernible color changes at specific pH intervals (Geetha & Sumathy, 2013). The majority of indicators are organic dyes with synthetic origins. Today, acid-base titrations are chosen using synthetic indicators. The current study can be utilized to investigate the colorant behavior of Tagetes erecta flowers and leaves, and additional testing is done on its potential usage as a natural dye (Elumalai et al., 2012).
## II. MATERIALS AND METHODS
bleached) was obtained from Masco Group (Gazipur 27, Tongi, Gazipur, Bangladesh). In Table 1, the fabric parameters are listed.
### a) Materials
100% cotton and 60/40 CVC single jersey knitted fabric in the ready-to-dye stage (scoured &
Table 1: Fabric Specifications
<table><tr><td>Fabric structure</td><td>Fabric Type</td><td>Count (Ne)</td><td>Grey WPI</td><td>Grey CPI</td><td>Finished WPI</td><td>Finished CPI</td><td>Weight GSM</td></tr><tr><td>Plain S/J</td><td>100% Cotton</td><td>30/s</td><td>31</td><td>50</td><td>34</td><td>53</td><td>145</td></tr><tr><td>Plain S/J</td><td>60/40 CVC</td><td>30/s</td><td>31</td><td>50</td><td>34</td><td>53</td><td>145</td></tr></table>
### b) Gathering of Plant-Based Supplies
The Tagetes erecta plant was gathered from Uttarkhan, Dhaka, Bangladesh. The obtained flower samples were transferred to the lab after being firmly packaged in plastic bags. The petals of the flowers were divided and separated from one another. Then, to remove dirt and dust, the petals were briefly surface-cleaned under running water two to three times.
### c) Chemicals
For the extraction of natural dye from Tagetes erecta leaves, all scientific-grade chemicals acquired from a local shop (Tongi, Dhaka, Bangladesh) were utilized.
 FeSO4
 CuSO4
 $\mathrm{k_2Cr_2O_7}$ Figure 1: Different Mordants $\mathrm{FeSO}_4$, $\mathrm{CuSO}_4$, and $\mathrm{K}_2\mathrm{Cr}_2\mathrm{O}_7$
### d) Preparation of Dyeextraction
## i. Alkaline Extraction
## ii. Mordant Preparation
Separately, 1gm of copper sulphate, ferrous sulphate, and potassium dichromate was dissolved in $100\mathrm{ml}$ of distilled water.
## iii. Fabric Preparation
Separately, 1gm of copper sulphate, ferrous sulphate, and potassium dichromate was dissolved in $100\mathrm{ml}$ of distilled water (Ahamed et al., 2017).
## iv. The Dyeing Process using a Simultaneous Technique
With this technique, $100\%$ cotton and $60/40$ CVC fabrics were dyed using dye extract and several chemical mordants, which were then fixed at $100^{\circ}\mathrm{C}$ for 20 minutes. The ordinary dye table of the plant dyes was compared (Aglawe et al., 2019).
## III. CHARACTERISATION
### a) Lightfastness
The fabric was left out in the sun for 24 hours. Colorfastness (IS-2454-85) was determined by comparing the color change of the subjected part to the color change of the original material that had not been exposed (Aglawe et al., 2019).
### a) Washing Fastness(IS-687-79)
The colored samples were sandwiched between two white, uncolored samples. These three separate parts were stitched together at the edges. The sandwiched fabric was placed in a vessel with the preheated soap solution (Tide at $55^{\circ}\mathrm{C}$ in the ratio of 1:50, i.e., 0.5g/25 ml water) and left for 45 minutes. The cloth was then taken out and washed in cold water(Nasrullah et al., 2012).


 Figure 2: a. Tagetes erecta plant; b. Grinding; and c. Liquid Dye Extraction
### b) Evaluation of Antibacterial Assay
The inhibition zone was determined using the Kirby-Bauer disc diffusion test and the antimicrobial efficacy of the experimental samples against the Staphylococcus aureus bacterium. On tryptone soya agar media, fresh subcultures of the bacterial strain (S. aureus) were created. Nine milliliters of tryptone soya broth were inoculated with one loopful of a freshly cultivated colony. From a newly cultured plate, one loopful of a colony was taken and used to inoculate $9\mathrm{ml}$ of tryptone soya broth. After that, the mixture was overnight kept at $37^{\circ}\mathrm{C}$ in an incubator to get the desired turbidity of 0.5 Mc Farland Standard $(1.5\times 10^{8}\mathrm{CFU / ml})$. The bacterial culture was sequentially diluted in normal saline to a bacterial cell concentration of $1.5\times 10^{5}$ CFU/ml. After evaluating the samples, the zone of inhibition (ZOI) was identified (Sun, 2016). Pelletizing knitted cloth into a 13 mm diameter disc on an agar plate produced the sample for the experiment. Samples were then incubated for 24 hours at $37^{\circ}\mathrm{C}$. After incubation, the plates were examined to check for the zone of inhibition encircling the treated sample (Gokarneshan, N & Velumani, 2018).
### c) Evaluation of Bonding Behavior by FTIR
The materials were analyzed using Fourier transform infrared spectroscopy (FTIR) (IR Prestige 21, Shimadzu, Japan). According to the infrared absorption with a resolution of $4\mathrm{cm}^{-1}$ and a frequency range of $600 - 4000\mathrm{cm}^{-1}$, spectrum data from the automated spectrohos copyprogram was used to pinpoint the precise chemical groups that predominated in the sample (Badr et al., 2016).
Figure 3: Inhibitory Zone Formation Surrounding Developing Samples (a. $100\%$ cotton with $\mathrm{FeSO}_4$; b. $100\%$ cotton with $\mathrm{CuSO}_4$; c. $100\%$ Cotton with $\mathrm{K}_2\mathrm{Cr}_2\mathrm{O}_7$; d. $60/40$ CVC with $\mathrm{FeSO}_4$; e. $60/40$ CVC with $\mathrm{CuSO}_4$; f. $60/40$ CVC with $\mathrm{K}_2\mathrm{Cr}_2\mathrm{O}_7$
### d) Measurement of Color Strength
K/S values were used to determine the color strength of the dyed $100\%$ Cotton and 60/40 CVC fabrics. The dyed materials' light reflectances were measured with a Text flash spectrophotometer (Data Color Corp.). The Kubelka-Munk equation was used to calculate the K/S values.
$$
\mathrm {K} / \mathrm {S} = (1 - \mathrm {R}) ^ {2} / 2 \mathrm {R}
$$
Where $R$ is the decimal fraction of the colored fabrics' maximum light reflectance ( $\lambda_{\max}$ ). The absorption coefficient is K, while the scattering coefficient is S (Habibzadeh et al., 2010).
## IV. RESULTS & DISCUSSION
### a) Evaluation of Light Fastness Properties
Excellent to moderate light fastness at $100^{\circ}\mathrm{C}$ fixed on $100\%$ cotton and $60/40$ CVC fabrics. The alkaline dye-extract of T. erecta with the mordant $\mathrm{CuSO}_4$, $\mathrm{FeSO}_4$ and $\mathrm{K}_2\mathrm{Cr}_2\mathrm{O}_7$ showed excellent to moderate light fastness at $100^{\circ}\mathrm{C}$ fixed $100\%$ cotton and $60/40$ CVC (Table 2). Likewise, the test specimen was dyed using marigold leaf extract and mordanted with iron and copper sulphate resulting in good light fastness. The resistance to dye attack is an inherent property of the
dye chromophore, however, the auxochrome can also significantly affect the fastness.
Table 2: Light Fastness Properties (IS-2454-85) of Samples Dyed with Leaves Extract from T. Erecta
<table><tr><td>Dye Extracts</td><td>Mordants</td><td>100% Cotton</td><td>60/40 CVC</td></tr><tr><td rowspan="3">Tagetes erecta dye extract at 100°C</td><td>Ferrous sulphate</td><td>Excellent</td><td>Good</td></tr><tr><td>Copper sulphate</td><td>Excellent</td><td>Moderate</td></tr><tr><td>Potassium dichromate</td><td>Excellent</td><td>Moderate</td></tr></table>
### b) Evaluation Of Wash Fastness Properties
At $100^{\circ} \mathrm{C}$ fixed $100\%$ cotton and 60/40 CVC materials, the washing fastness of T. erecta dye extract ranged from mild to good. At $100^{\circ} \mathrm{C}$, $100\%$ cotton and 60/40 CVC fabrics showed good washing fastness with mordant $\mathrm{FeSO}_{4}$ (Table 3). Likewise, the exceptional washing fastness of Cordia Sebestena flower extract dye can be successfully utilized for dyeing silk to achieve a wide range of soft and light colors by combining mordants. Using varied temperatures $(50^{\circ}\mathrm{C},$ $60^{\circ}\mathrm{C}$, and $70^{\circ}\mathrm{C})$ and different washing fastness hours (6h, 7h, and 8h) of various chemical mordants, the color fastness characteristics of the colorant derived from the brake of acacia leucophloeia on cotton have been examined. In the current study, various mordants were used for dyeing fabrics made of bleached cotton and CVC (Shinde et al., 2010).
Table 3: Wash Fastness Properties (IS-687-79) of Samples Dyed with Leaves Extract from T. Erecta
<table><tr><td>Dye Extracts</td><td>Mordants</td><td>100% Cotton</td><td>60/40 CVC</td></tr><tr><td rowspan="3">Tageteserecta dye extract at 100°C</td><td>Ferrous sulphate</td><td>Good</td><td>Moderate</td></tr><tr><td>Copper sulphate</td><td>Good</td><td>Mild</td></tr><tr><td>Potassium dichromate</td><td>Moderate</td><td>Mild</td></tr></table>
### c) Mordant Optimization using K/S Values and Color Hue Shifts
Various hues of color were obtained from postmordanted cotton and CVC fabric with ferrous sulphate, copper sulphate, and potassium dichromate as shown in table-4. Different mordants alter the brightness index values, L\* values, and K/S values in addition to affecting color shades and K/S values significantly (Jeyakodi & Venkataraman, 2015). The effect of mordants on color values of cotton and CVC fabrics dyed with leaves of Tageteserectais shown in Figure 4. Table 5 displays the values for $L^{\star}$, $a^{\star}$, $b^{\star}$, and $K/S$. As can be observed, mordants with higher $L^{\star}$ values produce lighter hues, while those with lower $L^{\star}$ values provide deeper shades for the sample fabrics. Similarly, green and blue are represented by negative values for $a^{\star}$ and $b^{\star}$, respectively. Among the chemical mordants used, the highestcolor value (K/S = 65.203) was obtained with ferrous sulphate,and the lowest color value (K/S = 23.985) with Potassium dichromate.60/40 CVC fabric showed a higher color value than the 100% cotton fabric.
Table 4: Color Produced on Cotton and CVC Fabric by Different Mordants in Post-Mordanting (POM)
<table><tr><td>S. No.</td><td>Fabric type</td><td>Mordants</td><td colspan="3">Color Obtained</td></tr><tr><td>1</td><td>100% Cotton</td><td>Ferrous sulphate</td><td></td><td></td><td></td></tr><tr><td>2</td><td>100% Cotton</td><td>Copper sulphate</td><td></td><td></td><td></td></tr><tr><td>3</td><td>100% Cotton</td><td>Potassium dichromate</td><td></td><td></td><td></td></tr><tr><td>4</td><td>60/40 CVC</td><td>Ferrous sulphate</td><td></td><td></td><td></td></tr><tr><td>5</td><td>60/40 CVC</td><td>Copper sulphate</td><td></td><td></td><td></td></tr><tr><td>6</td><td>60/40 CVC</td><td>Potassium dichromate</td><td></td><td></td><td></td></tr></table>
Table 5: L\*, a\*, b\*, and K/S Values for Cotton and CVC Fabric Colored with Tageteserecta Leaves, in Addition to others Post-Mordants
<table><tr><td>S. No.</td><td>Fabric type</td><td>Mordants</td><td>L*</td><td>a*</td><td>b*</td><td>K/S value</td></tr><tr><td>1</td><td>100% Cotton</td><td>Ferrous sulphate</td><td>69.817</td><td>0.599</td><td>19.785</td><td>65.203</td></tr><tr><td>2</td><td>100% Cotton</td><td>Copper sulphate</td><td>73.247</td><td>1.974</td><td>27.355</td><td>35.837</td></tr><tr><td>3</td><td>100% Cotton</td><td>Potassium dichromate</td><td>77.154</td><td>1.602</td><td>15.379</td><td>23.985</td></tr><tr><td>4</td><td>60/40 CVC</td><td>Ferrous sulphate</td><td>65.020</td><td>0.297</td><td>12.510</td><td>62.529</td></tr><tr><td>5</td><td>60/40 CVC</td><td>Copper sulphate</td><td>74.857</td><td>1.865</td><td>13.257</td><td>39.789</td></tr><tr><td>6</td><td>60/40 CVC</td><td>Potassium dichromate</td><td>74.300</td><td>0.495</td><td>9.741</td><td>36.946</td></tr></table>
 Figure 4: Post-Mordants' Impact on the Color Values of Dyed Cotton and CVC Fabrics
### d) Antibacterial Efficacy of the Alkaline Dye Extract from Tagetes erectas
The dye extract showed average antibacterial activity against Staphylococcus aureus bacteria. Among the six samples with three different mordants, 60/40 CVC samples dyed with T. erectas leaves extract along with copper sulphate as mordants showed more effectiveness against S. aureus bacteria where the zone of inhibition was $6 \pm 0.54 \mathrm{~mm}$ as shown in Table 6. In contrast, ferrous sulphate-containing samples showed less effectiveness against the bacteria. Moreover, 60/40 CVC samples showed higher results of antibacterial efficacy than $100\%$ cotton samples because polyester fiber itself influences bacterial resistance due to its hydrophobic nature (Pekhtasheva et al., 2011).
Table 6: Antibacterial Efficacy of Alkaline Dye Extract from Leaves Of T. Erecta
<table><tr><td>Sample</td><td>Mordants</td><td>Bacterial cell concentration (CFU/ml)</td><td>Sample weight (gm)</td><td>Disk size</td><td>Zone of inhibition (ZOI)</td></tr><tr><td>100% Cotton</td><td>Ferrous sulphate</td><td>1.5 x 105</td><td>5</td><td>7 mm x 7 mm</td><td>3±1.7 mm</td></tr><tr><td>100% Cotton</td><td>Copper sulphate</td><td>1.5 x 105</td><td>5</td><td>7 mm x 7 mm</td><td>4±1.9 mm</td></tr><tr><td>100% Cotton</td><td>Potassium dichromate</td><td>1.5 x 105</td><td>5</td><td>7 mm x 7 mm</td><td>4±1.4 mm</td></tr><tr><td>60/40 CVC</td><td>Ferrous sulphate</td><td>1.5 x 105</td><td>5</td><td>7 mm x 7 mm</td><td>3±0.86 mm</td></tr><tr><td>60/40 CVC</td><td>Copper sulphate</td><td>1.5 x 105</td><td>5</td><td>7 mm x 7 mm</td><td>6±0.54 mm</td></tr><tr><td>60/40 CVC</td><td>Potassium dichromate</td><td>1.5 x 105</td><td>5</td><td>7 mm x 7 mm</td><td>4±1.7 mm</td></tr></table>
### e) FTIR Spectra Investigation of the Dye Extracted from T. Erectas
By using FTIR spectroscopy, developed samples of both $100\%$ cotton and 60/40 CVC were examined to verify the requisite functional groups and internal bondings. Figure 5 depicts cotton fiber's FTIR spectrum, where typical bands of cellulose, lignin, and hemicellulose may be seen whereas in 60/40 cotton- polyester (figure 6) fabric sample, the FTIR spectra emerge the strong peaks like cotton and weak peaks like polyester due to the proportion of fiber composition (Lam et al., 2012). The T. erecta dye extract showed more absorption bands at 3286.7, 2929.87, 1955.82, 1718.58, 1365.6, and 721.38 that were assigned to the alcohol as a functional group, including O-H stretching, C-H stretching, N=C=S stretching, N-H bending, and
C-H rocking(Altameme et al., 2015). The alkaline dye extract of T. erecta contains several chemical components such as alcohol, amine, alkane, isothiocyanate, and alkyl halides (Fig. 5). There are no discernible variations in the sample of different mordants as shown in the figure.
 Panel label: a.
 Panel label: b.
 Panel label: c.
 Figure 5: FTIR Band Spectra of $100\%$ Cotton with Mordant a. $\mathrm{FeSO}_4$; b. $\mathrm{CuSO}_4$; c. $\mathrm{K}_2\mathrm{Cr}_2\mathrm{O}_7$ d
 Panel label: e.
 f Figure 6: FTIR Band Spectra of 60/40 CVC with Mordant a. $\mathrm{FeSO}_4$; b. $\mathrm{CuSO}_4$; c. $\mathrm{K}_2\mathrm{Cr}_2\mathrm{O}_7$
## V. CONCLUSION
Natural dye has a great opportunity in the usage of textile coloring due to its nonhazardous characteristics to the environment. The study found that the alkaline dye extract of T. erecta may be successfully used for dying cotton and CVC fabric when combined with various mordants. Dyeing with mordants had good washing and lightfastness, and the dye extract showed antibacterial efficacy. Moreover, the alkaline solution of leaf extracts of T. erecta showed satisfactory color strength and light reflectance. The dye has a wide range of scope in commercial cotton dyeing.
[^1]: filter paper was used to filter the dye. The acquired dye extract was kept in the refrigerator (Tripathi et al., 2015). _(p.2)_
[^20]: gm were measured and stored in an alkaline solution. Finally, it was exposed to high heat for 30 minutes at $90^{\circ}\mathrm{C}$. Whatman no. _(p.2)_
[^100]: cc of distilled water dissolved 1gm of Sodium Hydroxide (NaOH). T. erecta petals weighing 10 _(p.2)_
Generating HTML Viewer...
References
22 Cites in Article
Sachin Aglawe,Amol Gayke,Prasad Murade,Prashant Swami,Pramod Game,Pratik Kadam,Shubham Kanawade,Yogesh Garud (2019). Different methods of extraction for Red Dye from <i>Capsicum annuum</i>.
T Ahamed,S Rahman,A Shohael (2017). Thin layer chromatographic profiling and phytochemical screening of six medicinal plants in Bangladesh.
H Altameme,I Hameed,N Abu-Serag (2015). Analysis of bioactive phytochemical compounds of two medicinal plants, Equisetum arvense and Alchemila valgaris seed using gas chromatographymass spectrometry and fouriertransform infrared spectroscopy.
A Badr,A Hassanin,M Moursey (2016). Influence of Tencel/cotton blends on knitted fabric performance.
A Elumalai,M Eswariah,M Chinna,B Kumar (2012). An Alternative to Synthetic Acid Base Indicator-Tagetes Erecta Linn.
B Geetha,V Sumathy (2013). Extraction of natural dyes from plants.
N Gokarneshan,K Velumani (2018). Application of natural dyes to cotton and jute textiles: Science and technology and environmental issues.
S Habibzadeh,H Tayebi,E Ekrami,A Nateri,M Allahnia,M Bahmani (2010). Silk dyeing using saw-wood of the zelkoa forest tree.
M Jeyakodi,V Venkataraman (2015). Study of Dyeing, Absorbency, Mechanical and Surface Properties on Chemical Treated Cotton Fabric.
Y.-L Lam,C.-W Kan,C.-W Yuen (2012). Developments in functional finishing of cotton fibres--wrinkle-resistant, flame-retardant and antimicrobial treatments.
S Nasrullah,K Rahman,M Ikram,M Nisar,I Khan (2012). Screening of antibacterial activity of medicinal plants.
Geetha Paramasivam,Dhanya Manikandan,Sankaralingam Subbiah,Sugapriya Menaga Paulraj,Vasthi Gnana Rani,Mahendran Shunmugiah,Balasundaram Harinathan (2022). Extraction and Applications of Natural dye from the flower of Tagetes erecta.L in different Fabrics and Focus on Antimicrobial activity.
S Patil,D Kurlapkar,D Gaikwad (2016). Phytochemical Characterization of Natural Dye Extracted from Senna siamea Pods.
Elena Pekhtasheva,Anatoly Neverov,Stefan Kubica,Gennady Zaikov (2011). Biodegradation and Biodeterioration of Some Natural Polymers.
A Samanta,A Konar (2011). Dyeing of textiles with natural dyes.
P Saravanan,G Chandramohan,S Saivaraj,D Deepa (2013). Extraction and application of eco-friendly natural dye obtained from barks of Odina wodier L. on c otton fabric.
P Saravanan,G Chandramohan,J Mariajancyrani,P Shanmugasundaram (2013). Extraction and Application of Eco-Friendly Natural dye obtained from Leaves of Acalypha indica Linn on Cotton Fabric.
L Shetty,H Harikiran,J Fernandes (2009). Pharmacological evaluation of ethanolic extract of flowers of Tagetes erecta on epilepsy.
Lokesh Shetty,Farouk Sakr,Kais Al- Obaidy,Mohammed Patel,Hidayatullah Shareef (2015). A brief review on medicinal plant Tagetes erecta Linn.
N Shinde,R Saindane,S Bhosale,S Deshpande (2010). In vitro antioxidant activity of ethanolic and chloroform extracts of Tagetes erecta flowers.
G Sun (2016). Antimicrobial finishes for improving the durability and longevity of fabric structures.
G Tripathi,M Yadav,P Upadhyay,S Mishra (2015). Natural dyes with future aspects in dyeing of textiles: A research article.
No ethics committee approval was required for this article type.
Data Availability
Not applicable for this article.
How to Cite This Article
Sonjit Kumar Saha. 2026. \u201cEvaluation of Bactericidal Performances on Various Knitted Fabric Treated with the Natural Dye Extraction from Tagetes Erecta Leaves\u201d. Global Journal of Science Frontier Research - G: Bio-Tech & Genetics GJSFR-G Volume 23 (GJSFR Volume 23 Issue G1).
Explore published articles in an immersive Augmented Reality environment. Our platform converts research papers into interactive 3D books, allowing readers to view and interact with content using AR and VR compatible devices.
Your published article is automatically converted into a realistic 3D book. Flip through pages and read research papers in a more engaging and interactive format.
Our website is actively being updated, and changes may occur frequently. Please clear your browser cache if needed. For feedback or error reporting, please email [email protected]
Thank you for connecting with us. We will respond to you shortly.